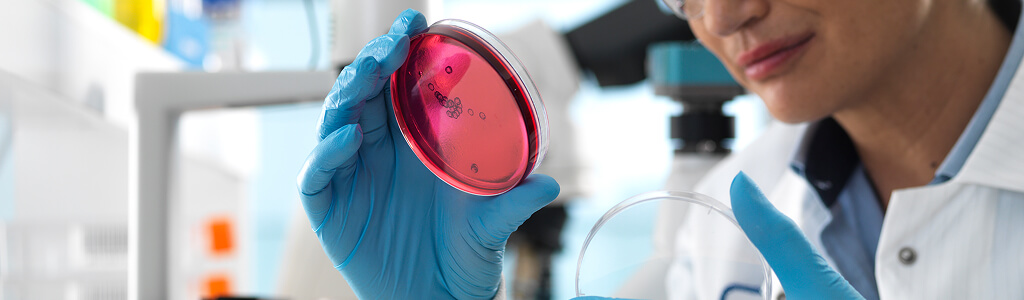
Understanding Phase1 In Data Governance Workflows

This background informs the technical and contextual discussion only and does not constitute clinical, legal, therapeutic, or compliance advice.
Scope
Informational intent related to enterprise data governance, focusing on the integration layer within regulated industries, specifically addressing phase1 workflows.
Planned Coverage
The primary intent type is informational, focusing on the enterprise data domain of laboratory data, within the integration system layer, addressing regulatory sensitivity in compliance workflows.
Introduction
Phase1 refers to a structured approach to managing data integration and compliance workflows in regulated environments, particularly in life sciences and pharmaceutical research. Organizations in these sectors often encounter challenges when dealing with large volumes of data from diverse sources, including laboratory instruments and laboratory information management systems (LIMS).
Problem Overview
In regulated environments, organizations face significant challenges in managing large volumes of data. The integration of diverse data sources presents hurdles in ensuring data quality, traceability, and compliance. Without a robust framework, organizations may experience data silos, leading to inefficiencies and potential regulatory non-compliance.
Key Takeaways
- The integration of phase1 can streamline assay data workflows significantly.
- Utilizing fields like
plate_idandsample_idallows for better tracking and management of experimental data. - A notable reduction in data processing time was observed when implementing phase1 solutions in compliance workflows.
- Establishing clear metadata governance models can enhance data traceability and auditability, which are critical in regulated environments.
Enumerated Solution Options
Organizations can explore various solutions to address their data management needs. These may include:
- Enterprise data management platforms that support large-scale integration.
- Custom ETL pipelines designed for specific research workflows.
- Cloud-based solutions for scalable data storage and processing.
- On-premise systems that ensure data security and compliance.
Comparison Table
| Solution | Scalability | Compliance | Cost |
|---|---|---|---|
| Enterprise Data Platform | High | Strong | Varies |
| Custom ETL Pipelines | Medium | Moderate | High |
| Cloud-Based Solutions | Very High | Strong | Varies |
| On-Premise Systems | Medium | Very Strong | High |
Deep Dive Option 1: Enterprise Data Management Platforms
One effective approach within phase1 is the implementation of enterprise data management platforms. These platforms facilitate the integration of various data sources, ensuring that data is normalized and prepared for analytics. By leveraging tools that support ingestion from laboratory instruments, organizations can streamline their workflows and enhance data quality.
Key data artifacts such as batch_id and run_id play a crucial role in tracking data lineage and ensuring compliance with regulatory standards.
Deep Dive Option 2: Custom ETL Pipelines
Another strategy involves the development of custom ETL pipelines tailored to specific research needs. These pipelines can be designed to handle complex data transformations and ensure that data is compliant with industry regulations. The use of qc_flag and normalization_method within these pipelines can significantly improve data integrity and usability.
Deep Dive Option 3: Cloud-Based Solutions
Cloud-based solutions offer flexibility and scalability for organizations looking to manage large datasets. These solutions can support secure access control and lineage tracking, which are essential for compliance in regulated environments. Utilizing fields like operator_id and model_version can enhance the traceability of data throughout its lifecycle.
Security and Compliance Considerations
When implementing phase1 solutions, organizations may prioritize security and compliance. This includes establishing governance frameworks that define data access controls and audit trails. Regular audits and assessments can help ensure that data management practices align with regulatory requirements.
Decision Framework
Organizations may consider several factors when selecting a solution for their data management needs. These include:
- The volume and complexity of data being managed.
- Regulatory requirements specific to their industry.
- Existing infrastructure and integration capabilities.
- Budget constraints and total cost of ownership.
Tooling Example Section
For organizations evaluating platforms for this purpose, various commercial and open-source tools exist. Options for enterprise data archiving and integration in this space can include platforms such as Solix EAI Pharma, among others designed for regulated environments.
What to Do Next
Organizations may begin by assessing their current data management practices and identifying areas for improvement. Engaging with stakeholders across departments can provide insights into specific needs and challenges. Additionally, exploring available tools and solutions can help organizations make informed decisions about their data management strategies.
FAQ
Q: What is phase1 in the context of data management?
A: Phase1 refers to a structured approach to managing data integration and compliance workflows in regulated environments, particularly in life sciences and pharmaceutical research.
Q: How can organizations ensure compliance with data management practices?
A: Organizations can ensure compliance by implementing robust governance frameworks, conducting regular audits, and utilizing tools that support data traceability and auditability.
Q: What are some key data artifacts to consider in phase1?
A: Important data artifacts include plate_id, well_id, sample_id, and compound_id, which are essential for tracking and managing experimental data.
Safety Notice: This draft is informational and has not been reviewed for clinical, legal, or compliance suitability. It should not be used as the basis for regulated decisions, patient care, or regulatory submissions. Consult qualified professionals for guidance in regulated or clinical contexts.
DISCLAIMER: THE CONTENT, VIEWS, AND OPINIONS EXPRESSED IN THIS BLOG ARE SOLELY THOSE OF THE AUTHOR(S) AND DO NOT REFLECT THE OFFICIAL POLICY OR POSITION OF SOLIX TECHNOLOGIES, INC., ITS AFFILIATES, OR PARTNERS. THIS BLOG IS OPERATED INDEPENDENTLY AND IS NOT REVIEWED OR ENDORSED BY SOLIX TECHNOLOGIES, INC. IN AN OFFICIAL CAPACITY. ALL THIRD-PARTY TRADEMARKS, LOGOS, AND COPYRIGHTED MATERIALS REFERENCED HEREIN ARE THE PROPERTY OF THEIR RESPECTIVE OWNERS. ANY USE IS STRICTLY FOR IDENTIFICATION, COMMENTARY, OR EDUCATIONAL PURPOSES UNDER THE DOCTRINE OF FAIR USE (U.S. COPYRIGHT ACT § 107 AND INTERNATIONAL EQUIVALENTS). NO SPONSORSHIP, ENDORSEMENT, OR AFFILIATION WITH SOLIX TECHNOLOGIES, INC. IS IMPLIED. CONTENT IS PROVIDED "AS-IS" WITHOUT WARRANTIES OF ACCURACY, COMPLETENESS, OR FITNESS FOR ANY PURPOSE. SOLIX TECHNOLOGIES, INC. DISCLAIMS ALL LIABILITY FOR ACTIONS TAKEN BASED ON THIS MATERIAL. READERS ASSUME FULL RESPONSIBILITY FOR THEIR USE OF THIS INFORMATION. SOLIX RESPECTS INTELLECTUAL PROPERTY RIGHTS. TO SUBMIT A DMCA TAKEDOWN REQUEST, EMAIL INFO@SOLIX.COM WITH: (1) IDENTIFICATION OF THE WORK, (2) THE INFRINGING MATERIAL’S URL, (3) YOUR CONTACT DETAILS, AND (4) A STATEMENT OF GOOD FAITH. VALID CLAIMS WILL RECEIVE PROMPT ATTENTION. BY ACCESSING THIS BLOG, YOU AGREE TO THIS DISCLAIMER AND OUR TERMS OF USE. THIS AGREEMENT IS GOVERNED BY THE LAWS OF CALIFORNIA.
-
 White Paper
White PaperEnterprise Information Architecture for Gen AI and Machine Learning
Download White Paper -

-

-

